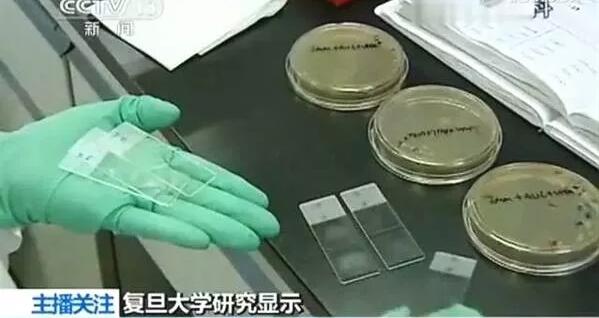
nj.jpg

疫苗問(wèn)題還未平息,抗生素問(wèn)題又禍起江浙滬,央視披露:江浙滬6成兒童體內(nèi)檢出獸用抗生素,如何守護(hù)孩子們?
近期,央視曝光了這樣一則讓人驚嘆的數(shù)據(jù):江浙滬竟有六成兒童體內(nèi)檢出獸用抗生素!
從1929年,弗萊明發(fā)現(xiàn)了青霉素,到1942年,青霉素大規(guī)模使用。

抗生素的出現(xiàn)幫人類(lèi)解決了很多問(wèn)題,但是問(wèn)題也隨之而來(lái)。疫苗問(wèn)題還未平息,抗生素問(wèn)題又禍起江浙滬。又一個(gè)周末,家長(zhǎng)圈又被“抗生素問(wèn)題”視頻刷爆,曾經(jīng)你微笑地喝著牛奶,愉快地啃著豬蹄或雞腿,那是我們最幸福的時(shí)刻,但有一天檢測(cè)你的血液,竟然流淌著獸用抗生素,我們?yōu)槟憔呐腼兊拿朗?,結(jié)果竟然是傷害你的毒品……

上海復(fù)旦大學(xué)公共衛(wèi)生學(xué)院之前做的一項(xiàng)研究,這項(xiàng)研究針對(duì)江蘇、浙江、上海1000多名8到11歲的在校兒童尿液進(jìn)行檢驗(yàn),結(jié)果顯示:近6成兒童檢出尿液中含有抗生素。
1、檢出畜禽用抗生素

化驗(yàn)結(jié)果表明,這1000個(gè)兒童中,至少有58%的兒童尿中檢出一種抗生素,四分之一的兒童尿中檢出2種以上抗生素,有的尿液樣本中能檢出6種抗生素。如果這類(lèi)成分長(zhǎng)期存在于體內(nèi),將對(duì)兒童的生長(zhǎng)發(fā)育造成不良影響。這次監(jiān)測(cè)還發(fā)現(xiàn),金霉素、恩諾沙星、泰樂(lè)菌素等三種一般只限于畜禽使用的抗生素,在兒童體內(nèi)均有檢出。要知道恩諾沙星,泰樂(lè)菌素對(duì)支原體有特效的抗生素,但都是僅限于畜禽和水產(chǎn)專(zhuān)用的,怎么會(huì)到孩子體內(nèi)呢?
2、環(huán)境食品或成暴露源

該課題組成員表示,他們研究發(fā)現(xiàn),此次從這1000名江浙滬兒童體內(nèi)檢測(cè)出了臨床上早已不推薦兒童中使用的抗生素成分,并且,這些抗生素成分在我們生活的環(huán)境和食品中也能經(jīng)常發(fā)現(xiàn)。換言之,不僅是臨床治療,環(huán)境與食品也可能成為抗生素的重要暴露源。
該結(jié)果表明,我國(guó)兒童普遍暴露于低劑量抗生素
3、吃肉,還是在“吃抗生素”?

根據(jù)《美國(guó)國(guó)家科學(xué)院院刊》上發(fā)表的一項(xiàng)研究,由于全球?qū)θ忸?lèi)食品的需求急劇上升,在豬肉、牛肉和禽肉中的抗生素含量也在急劇飆升。

同樣重量的豬肉要比牛肉多使用5倍的抗生素,比雞肉多使用2倍,在我國(guó),豬肉是主要的肉類(lèi)食品。
衛(wèi)生部合理用藥專(zhuān)家委員會(huì)委員肖教授表示,抗生素遺留主要有兩方面的原因。
一方面是農(nóng)業(yè)養(yǎng)殖業(yè)。
在大量的圈養(yǎng)的畜禽養(yǎng)殖中,很多畜禽會(huì)生病,于是會(huì)大量的使用抗生素。
而另一方面是人為原因:
比如藥品企業(yè)生產(chǎn)過(guò)程中的殘留殘?jiān)?,還有人們丟棄過(guò)期的藥物,都會(huì)導(dǎo)致環(huán)境中抗生素成分殘留。
通過(guò)食物鏈,層層遞進(jìn),抗生素就這樣光天化日侵入我們的體內(nèi)。
所以,中國(guó)兒童抗生素的廣泛暴露狀態(tài)可能加重細(xì)菌耐藥,從而威脅重要的臨床治療,也可能對(duì)兒童的生長(zhǎng)發(fā)育與人群健康造成潛在的危害。
4、抗生素的濫用
抗生素是用于治療各種細(xì)菌感染或抑制致病微生物感染的藥物,在中國(guó),抗生素的濫用尤其嚴(yán)重。據(jù)統(tǒng)計(jì),中國(guó)人平均每人每年要掛8瓶鹽水,遠(yuǎn)遠(yuǎn)高于國(guó)際上2.5~3.3瓶的水平,我國(guó)儼然已成“吊瓶大國(guó)”。
世衛(wèi)組織曾多次警告,如果中國(guó)不控制抗生素濫用,將害了全世界。有關(guān)資料顯示,中國(guó)是抗生素使用大國(guó),也是抗生素生產(chǎn)大國(guó):年產(chǎn)抗生素原料大約21萬(wàn)噸,出口3萬(wàn)噸,其余自用(包括醫(yī)療與農(nóng)業(yè)使用),人均年消費(fèi)量138克左右。
據(jù)2006-2007年度衛(wèi)生部全國(guó)細(xì)菌耐藥監(jiān)測(cè)結(jié)果顯示,全國(guó)醫(yī)院抗菌藥物年使用率高達(dá)74%。而世界上沒(méi)有哪個(gè)國(guó)家如此大規(guī)模地使用抗生素,在美英等發(fā)達(dá)國(guó)家,醫(yī)院的抗生素使用率僅為22%~25%。使用率超歐美三倍!
據(jù)1995-2007年疾病分類(lèi)調(diào)查,中國(guó)感染性疾病占全部疾病總發(fā)病數(shù)的49%,其中細(xì)菌感染性占全部疾病的18%-21%,也就是說(shuō)80%以上屬于濫用抗生素,每年有8萬(wàn)人因此死亡。這些數(shù)字使中國(guó)成為世界上濫用抗生素問(wèn)題最嚴(yán)重的國(guó)家之一。
在養(yǎng)殖業(yè)中,抗生素最初是用來(lái)預(yù)防動(dòng)物疾病的,在使用過(guò)程中,一些飼養(yǎng)者把抗生素的發(fā)酵殘?jiān)釉陲暳现形关i,并發(fā)現(xiàn)用這種飼料比用普通飼料飼喂的仔豬長(zhǎng)得更快。
Moore(1946)又發(fā)現(xiàn),在雞飼料中添加少量鏈霉素能促進(jìn)雛雞的生長(zhǎng)發(fā)育。以后許多人又陸續(xù)發(fā)現(xiàn)金霉素、地霉素等對(duì)犢牛、豬和禽等均有促進(jìn)生長(zhǎng)發(fā)育和育肥的作用。

在上個(gè)世紀(jì)60年代前后,有許多抗生素品種相繼問(wèn)世并工業(yè)化生產(chǎn),研究者們幾乎對(duì)每個(gè)新問(wèn)世的抗生素都作了以促進(jìn)動(dòng)物加速生長(zhǎng)為目的的飼養(yǎng)試驗(yàn)。研究結(jié)果肯定了多種抗生素具有刺激和加速動(dòng)物生長(zhǎng)的作用。這個(gè)消息很快在世界各地傳播開(kāi)來(lái),并引起各國(guó)的重視。
至此,抗生素作為畜禽飼料添加劑形成了一股極大的熱潮,全世界范圍內(nèi)都開(kāi)始使用,而且使用量日益增加。據(jù)估計(jì),我國(guó)每年抗生素原料生產(chǎn)量約為21萬(wàn)噸,其中有9.7萬(wàn)噸的抗生素用于畜牧養(yǎng)殖業(yè)。
隨著抗生素在飼料中長(zhǎng)期大量使用,細(xì)菌耐藥性和食品安全問(wèn)題也引起了全球的普遍關(guān)注。
5、濫用抗生素危害知多少
濫用抗生素使病原菌產(chǎn)生耐藥性細(xì)菌可通過(guò)三種方式獲得耐藥性,一是在細(xì)菌繁殖的二分裂階段通過(guò)代與代之間進(jìn)行傳遞。二是通過(guò)自發(fā)的基因突變產(chǎn)生。三是從附近其他的細(xì)菌細(xì)胞上獲得耐藥性基因。雖然耐藥性因子的傳遞頻率不高,但由于細(xì)菌數(shù)量大,繁殖快,仍易造成抗菌株的擴(kuò)散蔓延。

抗生素濫用導(dǎo)致耐藥菌株增加,而抗生素飼料添加劑長(zhǎng)期大量不合理使用是主要原因。
美國(guó)《新聞周刊》報(bào)道,僅1992年美國(guó)就有13300名患者死于抗生素耐藥性的細(xì)菌感染。
路透社1999年2月還報(bào)道了美國(guó)科學(xué)家在肉雞飼料中發(fā)現(xiàn)超級(jí)細(xì)菌,這種腸球菌對(duì)目前所有的抗生素具有耐藥性,超級(jí)細(xì)菌的產(chǎn)生給人類(lèi)疾病的治療帶來(lái)極大的困難。
抗生素在機(jī)體內(nèi)殘留,影響人和動(dòng)物的免疫和治療效果 當(dāng)機(jī)體攝入大量抗生素后,其跟隨血液循環(huán)遍布人體多個(gè)器官組織中,如淋巴結(jié)、腎、肺、骨骼、肝、脾、胸腺等各組織器官,造成動(dòng)物機(jī)體的免疫能力逐漸降低,使慢性疾病增多而且頻發(fā)。

同時(shí),抗生素還導(dǎo)致抗原質(zhì)量降低,對(duì)疫苗接種產(chǎn)生不良影響,為控制疫病的發(fā)生埋下了隱患。抗生素在治療人類(lèi)疾病和畜禽疾病中的效果逐漸變差,為了起到治病效果,抗生素的用量也在不斷增大,形成了惡性循環(huán)。
長(zhǎng)期超量使用抗生素,還易產(chǎn)生致病菌的交叉感染
使用抗生素,尤其是超量使用,會(huì)破壞腸道內(nèi)的微生態(tài)平衡,一方面使胃腸道內(nèi)對(duì)抗生素敏感性強(qiáng)的微生物減少,而敏感性差的菌群趁機(jī)大量繁殖,引起微生態(tài)失衡。
另一方面體內(nèi)的微生物被抗生素消滅后,為體外微生物的侵入繁殖創(chuàng)造了條件,從而易產(chǎn)生致病的交叉感染。

上海復(fù)旦大學(xué)公共衛(wèi)生學(xué)院的此項(xiàng)研究數(shù)據(jù)可能只是“冰山一角”,濫用抗生素帶來(lái)的不僅是對(duì)你我個(gè)體身體健康的威脅,更是需要重視的公共衛(wèi)生問(wèn)題。
6、舌尖上的安全不容忽視

對(duì)此,農(nóng)業(yè)部等部門(mén)高度重視,嚴(yán)格落實(shí)“四個(gè)最嚴(yán)”監(jiān)管,堅(jiān)持“產(chǎn)出來(lái)、管出來(lái)”兩手抓、兩手硬,多措并舉,努力保障人民群眾“舌尖上的安全”。
據(jù)悉,我國(guó)是養(yǎng)殖業(yè)大國(guó),也是獸用抗菌藥生產(chǎn)和使用大國(guó)。但是,當(dāng)前獸用抗菌藥市場(chǎng)秩序不夠規(guī)范、飼料生產(chǎn)和養(yǎng)殖環(huán)節(jié)用藥不盡合理、執(zhí)行休藥期規(guī)定不夠嚴(yán)、安全用藥意識(shí)不夠強(qiáng)等問(wèn)題突出,獸藥殘留監(jiān)控和動(dòng)物源細(xì)菌耐藥性防控體系還比較薄弱,養(yǎng)殖環(huán)節(jié)獸藥殘留超標(biāo)風(fēng)險(xiǎn)和細(xì)菌耐藥風(fēng)險(xiǎn)形勢(shì)依然嚴(yán)峻。
我國(guó)抗生素限制與歐美國(guó)家還有很大差距,積極完善相關(guān)法律法規(guī)依然是關(guān)鍵。
抗生素的發(fā)現(xiàn)無(wú)疑對(duì)人類(lèi)的身體健康有巨大的保障和好處,但是由于抗菌藥物的研發(fā)難度大,收益低,近年抗菌藥物的發(fā)展相當(dāng)慢,而耐藥菌又不斷出現(xiàn)給人類(lèi)敲響了警鐘。
以上這些,都說(shuō)明了我們國(guó)家抗生素濫用的狀況,抗生素一旦被濫用就會(huì)引起一些細(xì)菌和疾病的耐藥性,這一切都是我們沒(méi)有辦法控制的,國(guó)外已經(jīng)重視這種問(wèn)題了,希望我們國(guó)家也可以嚴(yán)格的管理抗生素的使用,還國(guó)人一個(gè)健康的生活環(huán)境。


